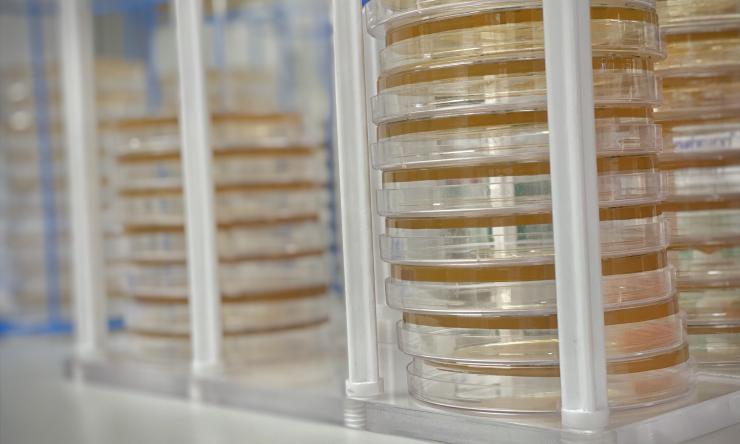
Mills Lab petri dishes

About the Lab
Dr. Jason Mills and his team investigate how functional cells can be called back into operation as stem cells in the process known as paligenosis, meaning the return to a regenerative state. The research team’s goal is to see whether paligenosis happens throughout the body and, most importantly, to determine how it plays a role in the origin of cancer.
Dr. Mills has studied stem cells and regeneration and cancer for more than 15 years and brings with him two instructors—Drs. Ramon Jin and Charles Cho, as well as a research graduate student and a postdoctoral fellow. Dr. Jin, who has a clinical interest in metaplasia, hopes to advance understanding around the origins of esophageal and gastric cancer as well as use the concept of paligenosis to optimize cancer therapy. Dr. Cho is studying the mechanics of how cells undergo paligenosis. The team also brings a large set of organoids—3-dimensional cells grown in the lab—which are derived from actual patients’ cancer cells as well as genetic mouse strains that have mutant genes for cancer origins.
The goal of the research is threefold: to prevent cancers, to find which lesions are the most dangerous and, in existing cancers, to understand what makes them continue. The lab members hope by targeting paligenosis, they can attack the abundance of cancer cells specifically, unlike current cancer therapy which attacks all proliferating cells, including the ones we need for the blood, skin, and digestive organs. Dr. Mills says “Given these organoid resources, we can grow cells from tumors; eventually, we will be able to screen different drugs for them to test for ideal treatment plans for particular types of cancer.”

Primary Investigator
View Dr. Jason Mills' bio for information about his background and research interests.

I foresee the ability to offer personalized medicine cancer patients by taking samples of their own cancer cells and determining in the lab the most effective treatment.


Meet Our Team
View a listing of the Mills Lab team members along with links to their bios.
Publications
View a listing of Mills Lab research publications that are published in PubMed and other scientific journals.

Construction of the Mills Lab
The Mills Lab research space construction is completed! Visit our news page to view the updates.

In the News
The American Association for the Advancement of Science featured Dr. Mills' research: Triggering autodegredation as mature cells begin regeneration.